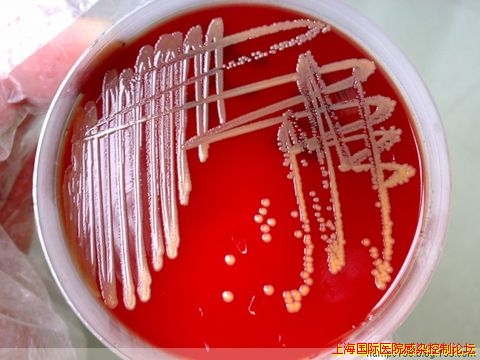

纤维单胞菌属拉丁学名[Cellulomonas (Bergey et al.,1923),Clark,1952] 在幼龄培养物中细胞为细长的不规则杆菌,0.5~0.6μm×2.0~5.0μm,直到稍弯,有的呈 V字状排列,偶见分支但无丝状体。老培养物的杆通常变短,有少数球状细胞出现。革兰阳性菌,但易褪色。常以一根或少数鞭毛运动。不生孢,不抗酸。兼性厌氧,有的菌株在厌氧条件下可生长但很差。在蛋白胨-酵母膏琼脂上的菌落通常凸起,淡黄色。化能异养菌,可呼吸代谢也可发酵代谢。从葡萄糖和其他碳水化合物在好氧和厌氧条件下都产酸。接触酶阳性。能分解纤维素。还原硝酸盐到亚硝酸盐。最适生长温度30℃。广泛分布于土壤和腐败的蔬菜。可引起菌血症。
我去年自一新生儿患者血液里分离出一株产黄纤维单胞菌(Cellulomonas flavigena),患者死了,所以无法继续考证其临床意义有多大。
菌落如图:
|
 /1
/1 